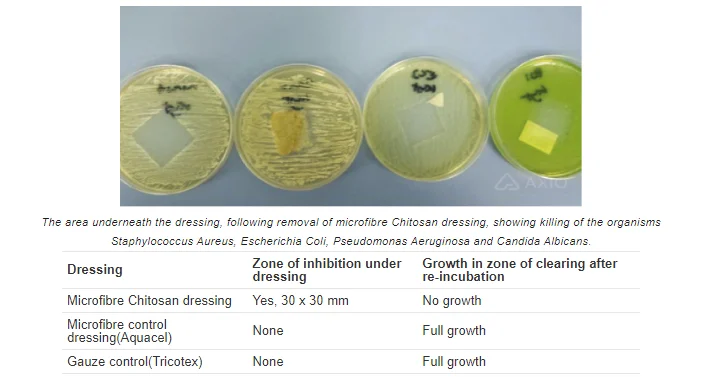

Maxiocel
A highly absorbent wound dressing, designed to heal patients suffering from chronic and infected wounds by effectively managing exudates, pain relief and infection.
Available Sizes

Select:
MaxioCel is a highly absorbent wound dressing, designed to heal patients suffering from chronic wounds by effectively managing exudates, pain relief and scar improvement. MaxioCel can be used for moderate to heavily exudating wounds of varied depth, shape and size.
Cohesive Gel Matrix for Exudate Management

- MaxioCel transforms into cohesive gel matrix on contact with wound exudates.
- Exudate lock-in.
- Micro-contouring, leaving no dead space for microorganism to grow
Cationic Action and Stimulation of Wound Healing

- Positively charged MaxioCel adheres to negatively charged blood.
- Accelerated granulation, re-epitheliazation.
- Increase oxygen level at wound site.
Wet Tensile Strength

- Remains intact during dressing change.
- Painless, easy removal by irrigating with saline.
- Does not disperse.
Composition
Non-woven Chitosan Microfibre dressing based on the unique Bioactive Microfibre Gelling Technology (BMG™)

Pain Management

Symptomatic relief at wound and periwound site by interaction with Bradykinin, interfering with the release of inflammatory mediators.
Antimicrobial Effect

Positively charged Chitosan bind to negatively charged microbial cell membranes, leading to cellular disruptions.
Haemostasis

Charge based adhesion, plasma sorption, platelet aggregation and activation of related pathways help in controlling capillary bleeds at wound site.
Scar Improvement

Collagen produced is in the form of fine reticular fibrils rather than mature bands of dense collagen which leads to scarring.
Wound Healing Process on Application of MaxioCel

Bioactive Microfiber Gelling Technology (BMG™ )
MaxioCel is the next-generation wound care dressing for both acute and chronic wound management, it utilizes Bioactive Microfiber Gelling (BMG) Technology, which leverages on Axio’s biopolymer platform. Gelling fiber dressings have become a mainstay in wound management due to their superior exudate absorption property. The BMG differs from currently available gelling fiber dressings in that the base material used is bioactive biopolymer which offers numerous benefits in wound healing. The BMG dressings not just offer superior exudate absorption and locking properties but also possesses excellent anti-microbial properties and promote wound healing at the cellular level.
The BMG dressings are manufactured using our proprietary patent-pending technology that purifies the biopolymer and makes it superabsorbent. The surface properties of these fibers are tailored in a way that they swell once exudate is absorbed but do not disintegrate when over-saturated, a common problem with currently available technologies. On absorbing the wound exudate, our BMG-based MaxioCel dressings transform into a cohesive and conformable gel. BMG technology-based gelling action in combination with unique molecular chemistry of biopolymer induces higher absorbency and mechanical strength to MaxioCel and facilitates the creation of an optimal environment for rapid wound healing.
BMG technology incorporates superabsorbent property to biopolymer fibers to lock-in the absorbed fluid within their fiber network chains significantly more than other wound care dressing through capillary action. When this wound dressing is used on highly exudating wounds, it sequesters the exudate fluid and damaged cell, infected necrotic tissue and bacteria present in it, thereby trapping them. This leads to well management of drainage and removal of cellular debris from the wound site. In a way it acts as an autolytic debridement agent. Its fluid retention, prevents wound maceration as well, keeping the wound clean and sufficiently moist.
In addition, BMG Technology helps to prevent maceration at wound site by wicking wound exudate fluid only vertically, not in lateral direction. Due to this vertical wicking property, MaxioCel dressing can easily hold the absorbed wound exudates for a longer period of time without spreading throughout the surrounding area. Moreover, BMG technology provide intimate contact for MaxioCel dressing at wound site due to electrostatic interaction between positively charged chitosan microfiber and negatively charged particles of necrotic tissue and cell debris. BMG Technology also delivers barrier to bacteria and broad-spectrum antimicrobial property to MaxioCel due to the presence of activated and positively charged chitosan microfiber.
- Chitosan absorbs blood plasma that leads to the concentration of erythrocytes and platelets in the injured place.
- Chitosan causes the adhesion, aggregation, and activation of platelets.
- Chitosan promotes erythrocyte coagulation and activation due to charge-based interaction.


Chitosan Promotes Re-Epithelialization
- Chitosan stimulates the proliferation of dermal fibroblast and allows fibrous tissue formation.
- Chitosan interacts with growth factors of serum and metal ions such as calcium that induce rapid proliferation of fibroblast.
- Chitosan inhibits the proliferation of keratinocytes.

Initial screening of chitin/Chitosan samples for effect on fibroblast proliferation in vitro. Human dermal fibroblasts (C520) were treated with various Chitosan samples for 3 days. The 3-H thymidine cell proliferation assay was then performed. Data (n=3 ±SEM) are presented as percentage of the controls (no polymer present) (*P (0.05, **P (0.01, ANOVA).
Antimicrobial Activity of Chitosan
- Cationic Chitosan binds to negatively charged cell walls of microorganisms which results in the leakage of proteinaceous and other intracellular constitutes
- Chitosan inhibits the mRNA and protein synthesis via the penetration of Chitosan into the nuclei of microorganisms.
- Chitosan provokes cell osmosis of the microorganisms.

Analgesic Effect Of Chitosan
- Chitosan absorbs the proton ions released at the inflammatory site.
- Chitin and Chitosan lower Bradykinin production at the inflammatory site.
- Chitosan also inhibits the Phospholipase A2. (PLA-2) activity, in turn blocking the Arachidonic acid pathway.

Anti-Inflammatory Property Of Chitosan
- Chitosan inhibits inflammation mediators such as Interleukin (IL)- 2, IL-4, IL-6, IL-10 and IL-13.
- Chitosan causes the reduction in pro-inflammatory cytokines such as TNF-a.
- Chitosan down regulates the NF-kf3 expression and AP-1 activation.

Scar Prevention by Chitosan
- Chitosan gradually degrades into N-acetyl-b-D-glucosamine, which initiates hyaluronic acid synthesis at the wound site that helps in faster scar improvement.
- In the presence of Chitosan, type IV collagen produced is in the form of fine reticulin like fibrils rather than mature bands of dense collagen which leads to scarring.
- Chitosan significantly decreases the expression of TGF-[31 factors by blocking the cyclooxygenase and arachidonic acid pathway that improve the scar.

Antimicrobial Assessment of a Chitosan Microfibre Dressing: A Natural Antimicrobial
Objective: This study was undertaken to assess the antimicrobial properties of the Chitosan-based microfibre namely Kytocel, wound dressing using a variety of methods commonly used to assess other antimicrobial dressings.
Method: The zone of inhibition (ZOI) assay, challenge test (log reduction), time-to-kill, and an in vitro wound model were all used in this report. Representative Gram-positive and Gram-negative bacteria were used and one yeast, Candida Albicans.
Results: The ZOI test showed no observable zones around the dressing but killed the organisms underneath the dressing. There was a >3 log reduction of Staphylococcus Aureus and Escherichia Coli within two hours and >3 log reduction against Pseudomonas Aeruginosa and Candida Albicans between four and 24 hours in the challenge test. In the wound model, there was a 2 log reduction of Escherichia Coli within the wound model and in the sponge and culture medium below the dressing.

Sequestration Test of 100% Chitosan Dressing
The color sequestration test of Chitosan wound dressing presented here shows the property of the Chitosan fibres to lock in the absorbed fluid within their chains.
- When the dressing is dipped in the colored solution, it rapidly turns into a gel and traps the color.
- The same dressing, when sequentially dipped in different colored solutions, shows a clear demarcation between the hydrated part with different colors and the dry part.
- The colors do not spread outside the defined stripes clearly indicating the extensive fluid retention capacity of the fibres.
- Finally, when the dressing is dipped in water, the water remains clear showing that the trapped colors aren’t released. When this wound dressing is used on highly exudating wounds, it sequesters the fluid and the cells and bacteria present in it, thereby trapping them. Its fluid retention, prevents wound maceration, keeping the wound clean and sufficiently moist. This creates a suitable environment for the wounds to heal.

Exudate absorption & locking
- Fluid absorption capacity: 30 times the weight of dressing.
- Once absorbed the exudate is locked within the fibres of the dressing.
- The gelling fibres prevent wicking of exudate into surrounding skin.
Lateral wicking of exudate from dressing may lead to leakage and maceration of surrounding skin. MaxioCel reduces the risk of maceration and leakage due to its unique vertical wicking properties. It can easily hold the absorbed wound exudates for a longer period of time without spreading throughout the surrounding area.

Dispersion Test & Wet Strength
Fluid absorption capacity: 30 times the weight of dressing. Wet strength of MaxioCel is around 3 times greater than the traditional gelling fibre dressing. Its outstanding strength makes it
- Intact during dressing change for a longer time.
- Painless easy removal from the wound surface.


Indications
- Cavity Wounds
- Donor Sites
- Diabetic Foot Ulcers
- Hemostasis post debridement
- Post Traumatic Wounds
- Pressure Ulcers
- Surgical Site Infections
- Venous Leg Ulcers
- Skin abrasions
- Superficial and partial thickness burns
- Surgical or post-operative wounds
Contraindications
- Individuals who are sensitive to or have had allergy to shellfish
Clinical Evidences
Clinical Publications

Maxiocel
A highly absorbent wound dressing, designed to heal patients suffering from chronic and infected wounds by effectively managing exudates, pain relief and infection.
Available Sizes
10cm x 10cm 2.5cm x 30cmContact Us
MaxioCel is a highly absorbent wound dressing, designed to heal patients suffering from chronic wounds by effectively managing exudates, pain relief and scar improvement. MaxioCel can be used for moderate to heavily exudating wounds of varied depth, shape and size.
Cohesive Gel Matrix for Exudate Management

- MaxioCel transforms into cohesive gel matrix on contact with wound exudates.
- Exudate lock-in.
- Micro-contouring, leaving no dead space for microorganism to grow
Cationic Action and Stimulation of Wound Healing

- Positively charged MaxioCel adheres to negatively charged blood.
- Accelerated granulation, re-epitheliazation.
- Increase oxygen level at wound site.
Wet Tensile Strength

- Remains intact during dressing change.
- Painless, easy removal by irrigating with saline.
- Does not disperse.
Composition
Non-woven Chitosan Microfibre dressing based on the unique Bioactive Microfibre Gelling Technology (BMG™)

Pain Management

Symptomatic relief at wound and periwound site by interaction with Bradykinin, interfering with the release of inflammatory mediators.
Antimicrobial Effect

Positively charged Chitosan bind to negatively charged microbial cell membranes, leading to cellular disruptions.
Haemostasis

Charge based adhesion, plasma sorption, platelet aggregation and activation of related pathways help in controlling capillary bleeds at wound site.
Scar Improvement

Collagen produced is in the form of fine reticular fibrils rather than mature bands of dense collagen which leads to scarring.
Wound Healing Process on Application of MaxioCel

Bioactive Microfiber Gelling Technology (BMG™ )
MaxioCel is the next-generation wound care dressing for both acute and chronic wound management, it utilizes Bioactive Microfiber Gelling (BMG) Technology, which leverages on Axio’s biopolymer platform. Gelling fiber dressings have become a mainstay in wound management due to their superior exudate absorption property. The BMG differs from currently available gelling fiber dressings in that the base material used is bioactive biopolymer which offers numerous benefits in wound healing. The BMG dressings not just offer superior exudate absorption and locking properties but also possesses excellent anti-microbial properties and promote wound healing at the cellular level.
The BMG dressings are manufactured using our proprietary patent-pending technology that purifies the biopolymer and makes it superabsorbent. The surface properties of these fibers are tailored in a way that they swell once exudate is absorbed but do not disintegrate when over-saturated, a common problem with currently available technologies. On absorbing the wound exudate, our BMG-based MaxioCel dressings transform into a cohesive and conformable gel. BMG technology-based gelling action in combination with unique molecular chemistry of biopolymer induces higher absorbency and mechanical strength to MaxioCel and facilitates the creation of an optimal environment for rapid wound healing.
BMG technology incorporates superabsorbent property to biopolymer fibers to lock-in the absorbed fluid within their fiber network chains significantly more than other wound care dressing through capillary action. When this wound dressing is used on highly exudating wounds, it sequesters the exudate fluid and damaged cell, infected necrotic tissue and bacteria present in it, thereby trapping them. This leads to well management of drainage and removal of cellular debris from the wound site. In a way it acts as an autolytic debridement agent. Its fluid retention, prevents wound maceration as well, keeping the wound clean and sufficiently moist.
In addition, BMG Technology helps to prevent maceration at wound site by wicking wound exudate fluid only vertically, not in lateral direction. Due to this vertical wicking property, MaxioCel dressing can easily hold the absorbed wound exudates for a longer period of time without spreading throughout the surrounding area. Moreover, BMG technology provide intimate contact for MaxioCel dressing at wound site due to electrostatic interaction between positively charged chitosan microfiber and negatively charged particles of necrotic tissue and cell debris. BMG Technology also delivers barrier to bacteria and broad-spectrum antimicrobial property to MaxioCel due to the presence of activated and positively charged chitosan microfiber.
- Chitosan absorbs blood plasma that leads to the concentration of erythrocytes and platelets in the injured place.
- Chitosan causes the adhesion, aggregation, and activation of platelets.
- Chitosan promotes erythrocyte coagulation and activation due to charge-based interaction.


Chitosan Promotes Re-Epithelialization
- Chitosan stimulates the proliferation of dermal fibroblast and allows fibrous tissue formation.
- Chitosan interacts with growth factors of serum and metal ions such as calcium that induce rapid proliferation of fibroblast.
- Chitosan inhibits the proliferation of keratinocytes.

Initial screening of chitin/Chitosan samples for effect on fibroblast proliferation in vitro. Human dermal fibroblasts (C520) were treated with various Chitosan samples for 3 days. The 3-H thymidine cell proliferation assay was then performed. Data (n=3 ±SEM) are presented as percentage of the controls (no polymer present) (*P (0.05, **P (0.01, ANOVA).
Antimicrobial Activity of Chitosan
- Cationic Chitosan binds to negatively charged cell walls of microorganisms which results in the leakage of proteinaceous and other intracellular constitutes
- Chitosan inhibits the mRNA and protein synthesis via the penetration of Chitosan into the nuclei of microorganisms.
- Chitosan provokes cell osmosis of the microorganisms.

Analgesic Effect Of Chitosan
- Chitosan absorbs the proton ions released at the inflammatory site.
- Chitin and Chitosan lower Bradykinin production at the inflammatory site.
- Chitosan also inhibits the Phospholipase A2. (PLA-2) activity, in turn blocking the Arachidonic acid pathway.

Anti-Inflammatory Property Of Chitosan
- Chitosan inhibits inflammation mediators such as Interleukin (IL)- 2, IL-4, IL-6, IL-10 and IL-13.
- Chitosan causes the reduction in pro-inflammatory cytokines such as TNF-a.
- Chitosan down regulates the NF-kf3 expression and AP-1 activation.

Scar Prevention by Chitosan
- Chitosan gradually degrades into N-acetyl-b-D-glucosamine, which initiates hyaluronic acid synthesis at the wound site that helps in faster scar improvement.
- In the presence of Chitosan, type IV collagen produced is in the form of fine reticulin like fibrils rather than mature bands of dense collagen which leads to scarring.
- Chitosan significantly decreases the expression of TGF-[31 factors by blocking the cyclooxygenase and arachidonic acid pathway that improve the scar.

Antimicrobial Assessment of a Chitosan Microfibre Dressing: A Natural Antimicrobial
Objective: This study was undertaken to assess the antimicrobial properties of the Chitosan-based microfibre namely Kytocel, wound dressing using a variety of methods commonly used to assess other antimicrobial dressings.
Method: The zone of inhibition (ZOI) assay, challenge test (log reduction), time-to-kill, and an in vitro wound model were all used in this report. Representative Gram-positive and Gram-negative bacteria were used and one yeast, Candida Albicans.
Results: The ZOI test showed no observable zones around the dressing but killed the organisms underneath the dressing. There was a >3 log reduction of Staphylococcus Aureus and Escherichia Coli within two hours and >3 log reduction against Pseudomonas Aeruginosa and Candida Albicans between four and 24 hours in the challenge test. In the wound model, there was a 2 log reduction of Escherichia Coli within the wound model and in the sponge and culture medium below the dressing.
Sequestration Test of 100% Chitosan Dressing
The color sequestration test of Chitosan wound dressing presented here shows the property of the Chitosan fibres to lock in the absorbed fluid within their chains.
- When the dressing is dipped in the colored solution, it rapidly turns into a gel and traps the color.
- The same dressing, when sequentially dipped in different colored solutions, shows a clear demarcation between the hydrated part with different colors and the dry part.
- The colors do not spread outside the defined stripes clearly indicating the extensive fluid retention capacity of the fibres.
- Finally, when the dressing is dipped in water, the water remains clear showing that the trapped colors aren’t released. When this wound dressing is used on highly exudating wounds, it sequesters the fluid and the cells and bacteria present in it, thereby trapping them. Its fluid retention, prevents wound maceration, keeping the wound clean and sufficiently moist. This creates a suitable environment for the wounds to heal.

Exudate absorption & locking
- Fluid absorption capacity: 30 times the weight of dressing.
- Once absorbed the exudate is locked within the fibres of the dressing.
- The gelling fibres prevent wicking of exudate into surrounding skin.
Lateral wicking of exudate from dressing may lead to leakage and maceration of surrounding skin. MaxioCel reduces the risk of maceration and leakage due to its unique vertical wicking properties. It can easily hold the absorbed wound exudates for a longer period of time without spreading throughout the surrounding area.

Dispersion Test & Wet Strength
Fluid absorption capacity: 30 times the weight of dressing. Wet strength of MaxioCel is around 3 times greater than the traditional gelling fibre dressing. Its outstanding strength makes it
- Intact during dressing change for a longer time.
- Painless easy removal from the wound surface.


Indications
- Cavity Wounds
- Donor Sites
- Diabetic Foot Ulcers
- Hemostasis post debridement
- Post Traumatic Wounds
- Pressure Ulcers
- Surgical Site Infections
- Venous Leg Ulcers
- Skin abrasions
- Superficial and partial thickness burns
- Surgical or post-operative wounds
Contraindications
- Individuals who are sensitive to or have had allergy to shellfish

